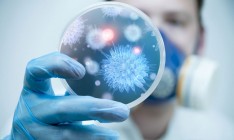

Государственная служба по вопросам безопасности пищевых продуктов и защиты потребителей ввела запрет на импорт птицы, мяса птицы и субпродуктов из Австрии. Об этом сообщает Госпотребслужба, передает Капитал.
Импорт запретили из-за вспышки высокопатогенного гриппа птиц (ВПГП), которые были зарегистрированы в хозяйствах на территории Австрии.
За это украинская сторона ввела ограничения на ввоз из Австрии птицы, продуктов и сырья из нее, за исключением продуктов и сырья, которые прошли обработку методом, который гарантирует уничтожение возбудителей указанных заболеваний.
e-mail: [email protected]
Ідеї оформлення, стиль та весь зміст сайту www.capital.ua є об'єктом авторського права та охороняються законом. Будь-яке використання матеріалів сайту допускається тільки при дотриманні правил передруку і за наявності гіперпосилання на www.capital.ua. Дозволяється використання тільки матеріалів, що знаходяться у відкритому доступі і лише за умови посилання та/або прямого відкритого для пошукових систем гіперпосилання на безпосередню адресу матеріалу на www.capital.ua www.capital.ua /a>. Посилання/гіперпосилання має бути розміщене в підзаголовку або першому абзаці матеріалу. Розмір шрифту посилання або гіперпосилання не повинен бути меншим за шрифт тексту використовуваного матеріалу. Будь-яке використання матеріалів, які знаходяться у закритому доступі та доступні лише зареєстрованим користувачам, допускається лише за попереднім письмовим дозволом правовласника. Категорично заборонено передрук, копіювання, відтворення, зміну або інше використання матеріалів, опублікованих з позначкою в рамках угоди про синдикацію з Financial Times Limited. Використання матеріалів, які містять посилання на агентства France-Presse, Reuters, Інтерфакс-Україна, Українські новини, УНІАН суворо заборонено. Матеріали, позначені знаком
публікуються на правах реклами.
Всі права захищені. © 2012 - 2023